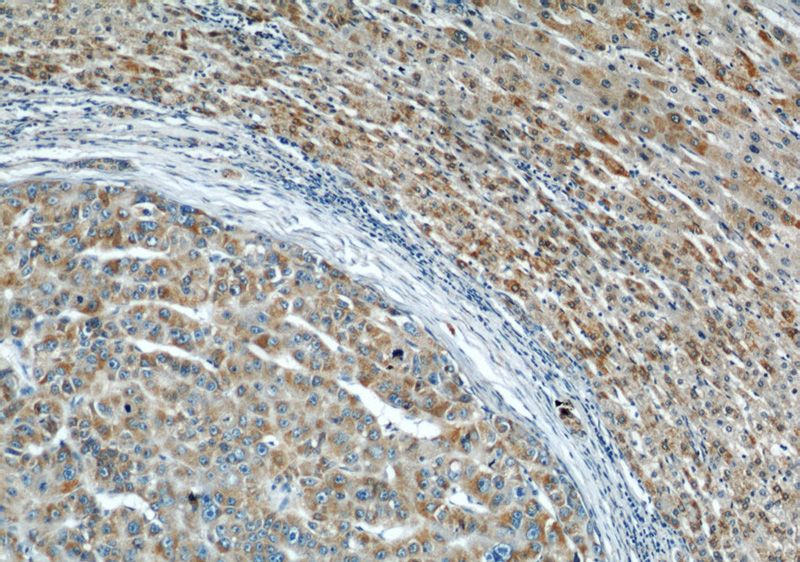
Immunohistochemical of paraffin-embedded human liver cancer using Catalog No:114216(PHB antibody) at dilution of 1:50 (under 10x lens)
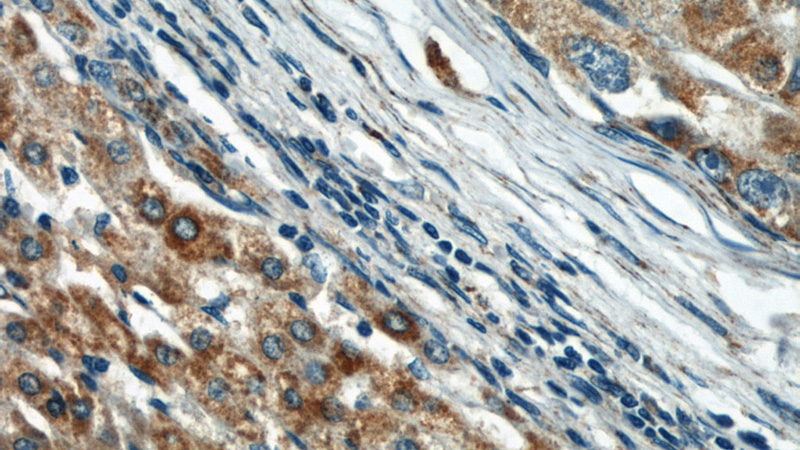
Immunohistochemical of paraffin-embedded human liver cancer using Catalog No:114216(PHB antibody) at dilution of 1:50 (under 40x lens)

-
Product Name
Prohibitin antibody
- Documents
-
Description
Prohibitin Rabbit Polyclonal antibody. Positive IHC detected in human liver cancer tissue, human heart tissue. Positive IF detected in A431 cells. Positive WB detected in HeLa cells, A431 cells, human brain tissue, human liver tissue, Jurkat cells, mouse brain tissue, mouse heart tissue, mouse liver tissue, NIH/3T3 cells, Raji cells, rat brain tissue, rat heart tissue. Observed molecular weight by Western-blot: 30 kDa
-
Tested applications
ELISA, IHC, WB, IF
-
Species reactivity
Human,Mouse,Rat; other species not tested.
-
Alternative names
PHB antibody; PHB1 antibody; prohibitin antibody
-
Isotype
Rabbit IgG
-
Preparation
This antibody was obtained by immunization of Prohibitin recombinant protein (Accession Number: NM_001281715). Purification method: Antigen affinity purified.
-
Clonality
Polyclonal
-
Formulation
PBS with 0.1% sodium azide and 50% glycerol pH 7.3.
-
Storage instructions
Store at -20℃. DO NOT ALIQUOT
-
Applications
Recommended Dilution:
WB: 1:500-1:5000
IHC: 1:20-1:200
IF: 1:10-1:100
-
Validations
Immunohistochemical of paraffin-embedded human liver cancer using Catalog No:114216(PHB antibody) at dilution of 1:50 (under 10x lens)
Immunohistochemical of paraffin-embedded human liver cancer using Catalog No:114216(PHB antibody) at dilution of 1:50 (under 40x lens)

Immunofluorescent analysis of A431 cells using Catalog No:114216(Prohibitin Antibody) at dilution of 1:25 and FITC-Goat anti-Rabbit IgG

HeLa cells were subjected to SDS PAGE followed by western blot with Catalog No:114216(PHB antibody) at dilution of 1:1000
-
Background
Prohibitin, also known as PHB, a member of the Band-7 family of proteins, is widely distributed in bacteria, plants, yeast, protozoa and mammals and is important in cell proliferation, differentiation and apoptosis (PMID: 20840588 ). This protein localizes to the inner membrane of mitochondria, where it acts as a chaperone protein, and is also found in the nucleus, where it negatively regulates transcription (PMID: 18558096). Recent study confirmed that the expression and distribution of PHB, which is a nuclear matrix protein, affect the apoptosis of HaCaT cells and its co-localization with specific gene products connected with cell apoptosis (PMID: 24402549).
-
References
- McCray BA, Skordalakes E, Taylor JP. Disease mutations in Rab7 result in unregulated nucleotide exchange and inappropriate activation. Human molecular genetics. 19(6):1033-47. 2010.
- Liu C, Zhang A, Guo J. Identification of human host proteins contributing to H5N1 influenza virus propagation by membrane proteomics. Journal of proteome research. 11(11):5396-405. 2012.
- Yang MS, Wang HS, Wang BS. A comparative proteomic study identified calreticulin and prohibitin up-regulated in adrenocortical carcinomas. Diagnostic pathology. 8:58. 2013.
- Chu BB, Liao YC, Qi W. Cholesterol transport through lysosome-peroxisome membrane contacts. Cell. 161(2):291-306. 2015.
- Li H, Ruan Y, Zhang K. Mic60/Mitofilin determines MICOS assembly essential for mitochondrial dynamics and mtDNA nucleoid organization. Cell death and differentiation. 23(3):380-92. 2016.
- Guo CC, Zheng LH, Fu JY. Antiosteoporotic Effects of Huangqi Sanxian Decoction in Cultured Rat Osteoblasts by Proteomic Characterization of the Target and Mechanism. Evidence-based complementary and alternative medicine : eCAM. 2015:514063. 2015.
Related Products / Services
Please note: All products are "FOR RESEARCH USE ONLY AND ARE NOT INTENDED FOR DIAGNOSTIC OR THERAPEUTIC USE"
